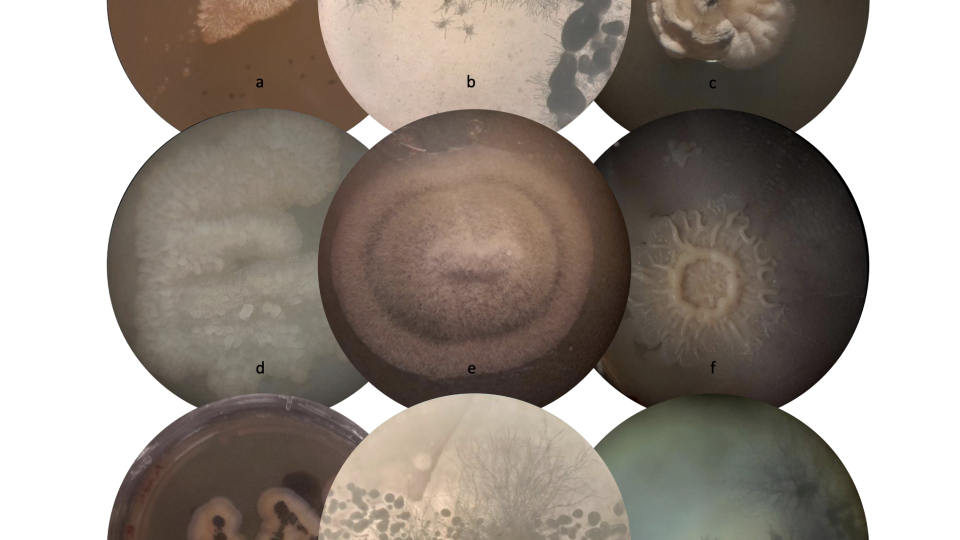
cultivos

The organisms on Earth that endure the most UV radiation are high-altitude lichens.
Tropical trees can replace UV-damaged leaves rapidly, while desert animals either produce their own shade or seek shaded shelter. But mountain lichens can't move, grow slowly, depend on access to light for energy, and are under a thinner layer of atmosphere, which means that their cells must have developed mechanisms for surviving under extreme exposure to UV radiation. Discovering these biochemical mechanisms promises great biotechnological applications.
But for this, the lichens need to be cultured in a lab. Fellow Dr. Erika Calla Quispe is working with andean lichens from Peru and went to the University of Buenos Aires to train on how to isolate and gorw mycobionts and endolichenic fungi outside of their very complex symbiotic assemblages, to advance research into the molecular mechanisms of UV radiation tolerance of lichens, which discoveries could eventually open the door to many exciting applications like materials resistant to UV light, more productive crops, and therapies against cellular damage.
We are thankful to her mentors, Dr. Alfredo Ibañez Gabilondo (Pontificia Universidad Católica de Perú) and Dr. Alejandra Fazio (UBA), for exploring this bioprospective path.